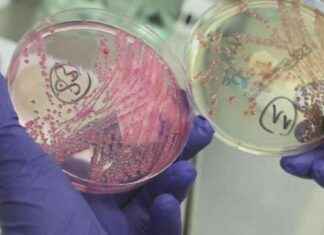
Recent E. coli Outbreak in St. Charles County: What You Need to Know recent-e-coli-outbreak-in-st-charles-county-what-you-need-to-know

Rachel Thompson
609 POSTS
0 COMMENTS
Rachel Thompson thrives in the fast-paced world of breaking news, delivering accurate and timely updates on national and global events. Her career spans coverage of natural disasters, elections, and major social movements. In her downtime, Rachel enjoys writing fiction and baking.
Expertise: Breaking news, disaster response, human rights issues.
Education: Bachelor’s in Communication, Northwestern University.
Understanding the Impact of the 5.7 Magnitude Earthquake near Yerington
A 5.7 magnitude earthquake rocked the area near Yerington just four hours ago, sending shockwaves through the community. This seismic event was quickly followed...
Mariachi Herencia de México: Modern Twist on Traditional Music – Chicago Reader
Mariachi Herencia de México: A Modern Twist on Traditional Music
In the heart of Chicago, a musical revolution is taking place, blending the rich history...
Recent E. coli Outbreak in St. Charles County: What You Need to Know
E. coli Outbreak in St. Charles County: Insights and Impact
In a shocking turn of events, a new lawsuit has emerged in St....
2025 Stadium Shows: System of a Down, Deftones, Avenged Sevenfold, Korn
System of a Down Announces Epic Stadium Shows
System of a Down, the iconic rock band, has just dropped some major news that has fans...
Paradigm Raises $16 Million for Global Phase 3 Clinical Trial
Paradigm Biopharmaceuticals Secures $16 Million for Phase 3 Clinical Trial
In a groundbreaking development, Paradigm Biopharmaceuticals (ASX:PAR) has successfully raised $16 million for its upcoming...
Whoopi Goldberg vs. Ana Navarro: ‘The View’ Clash over Donald Trump Panic
Whoopi Goldberg and Ana Navarro Clash on 'The View'
Whoopi Goldberg and Ana Navarro, cohosts on 'The View,' engaged in a rare squabble on Monday's...
Watch Men’s Jimmy V Classic: ESPN Schedule & Details
Jimmy V Classic 2024: ESPN Schedule & Details
The men's Jimmy V Classic is set to return once again this year, bringing together some of...
Jay-Z Denies Accusations of Child Rape at Awards After-Party: Extortion Allegations – WSVN 7News
Jay-Z Denies Extortion Allegations Amid Child Rape Accusations
On a night that should have been filled with celebration and accolades, rapper Jay-Z finds himself embroiled...
Apply for the Chicago Reader Spring Editorial Internship Today
Apply for the Chicago Reader Spring Editorial Internship Today
The Reader Institute for Community Journalism (RICJ), the organization behind the Chicago Reader, is thrilled to...